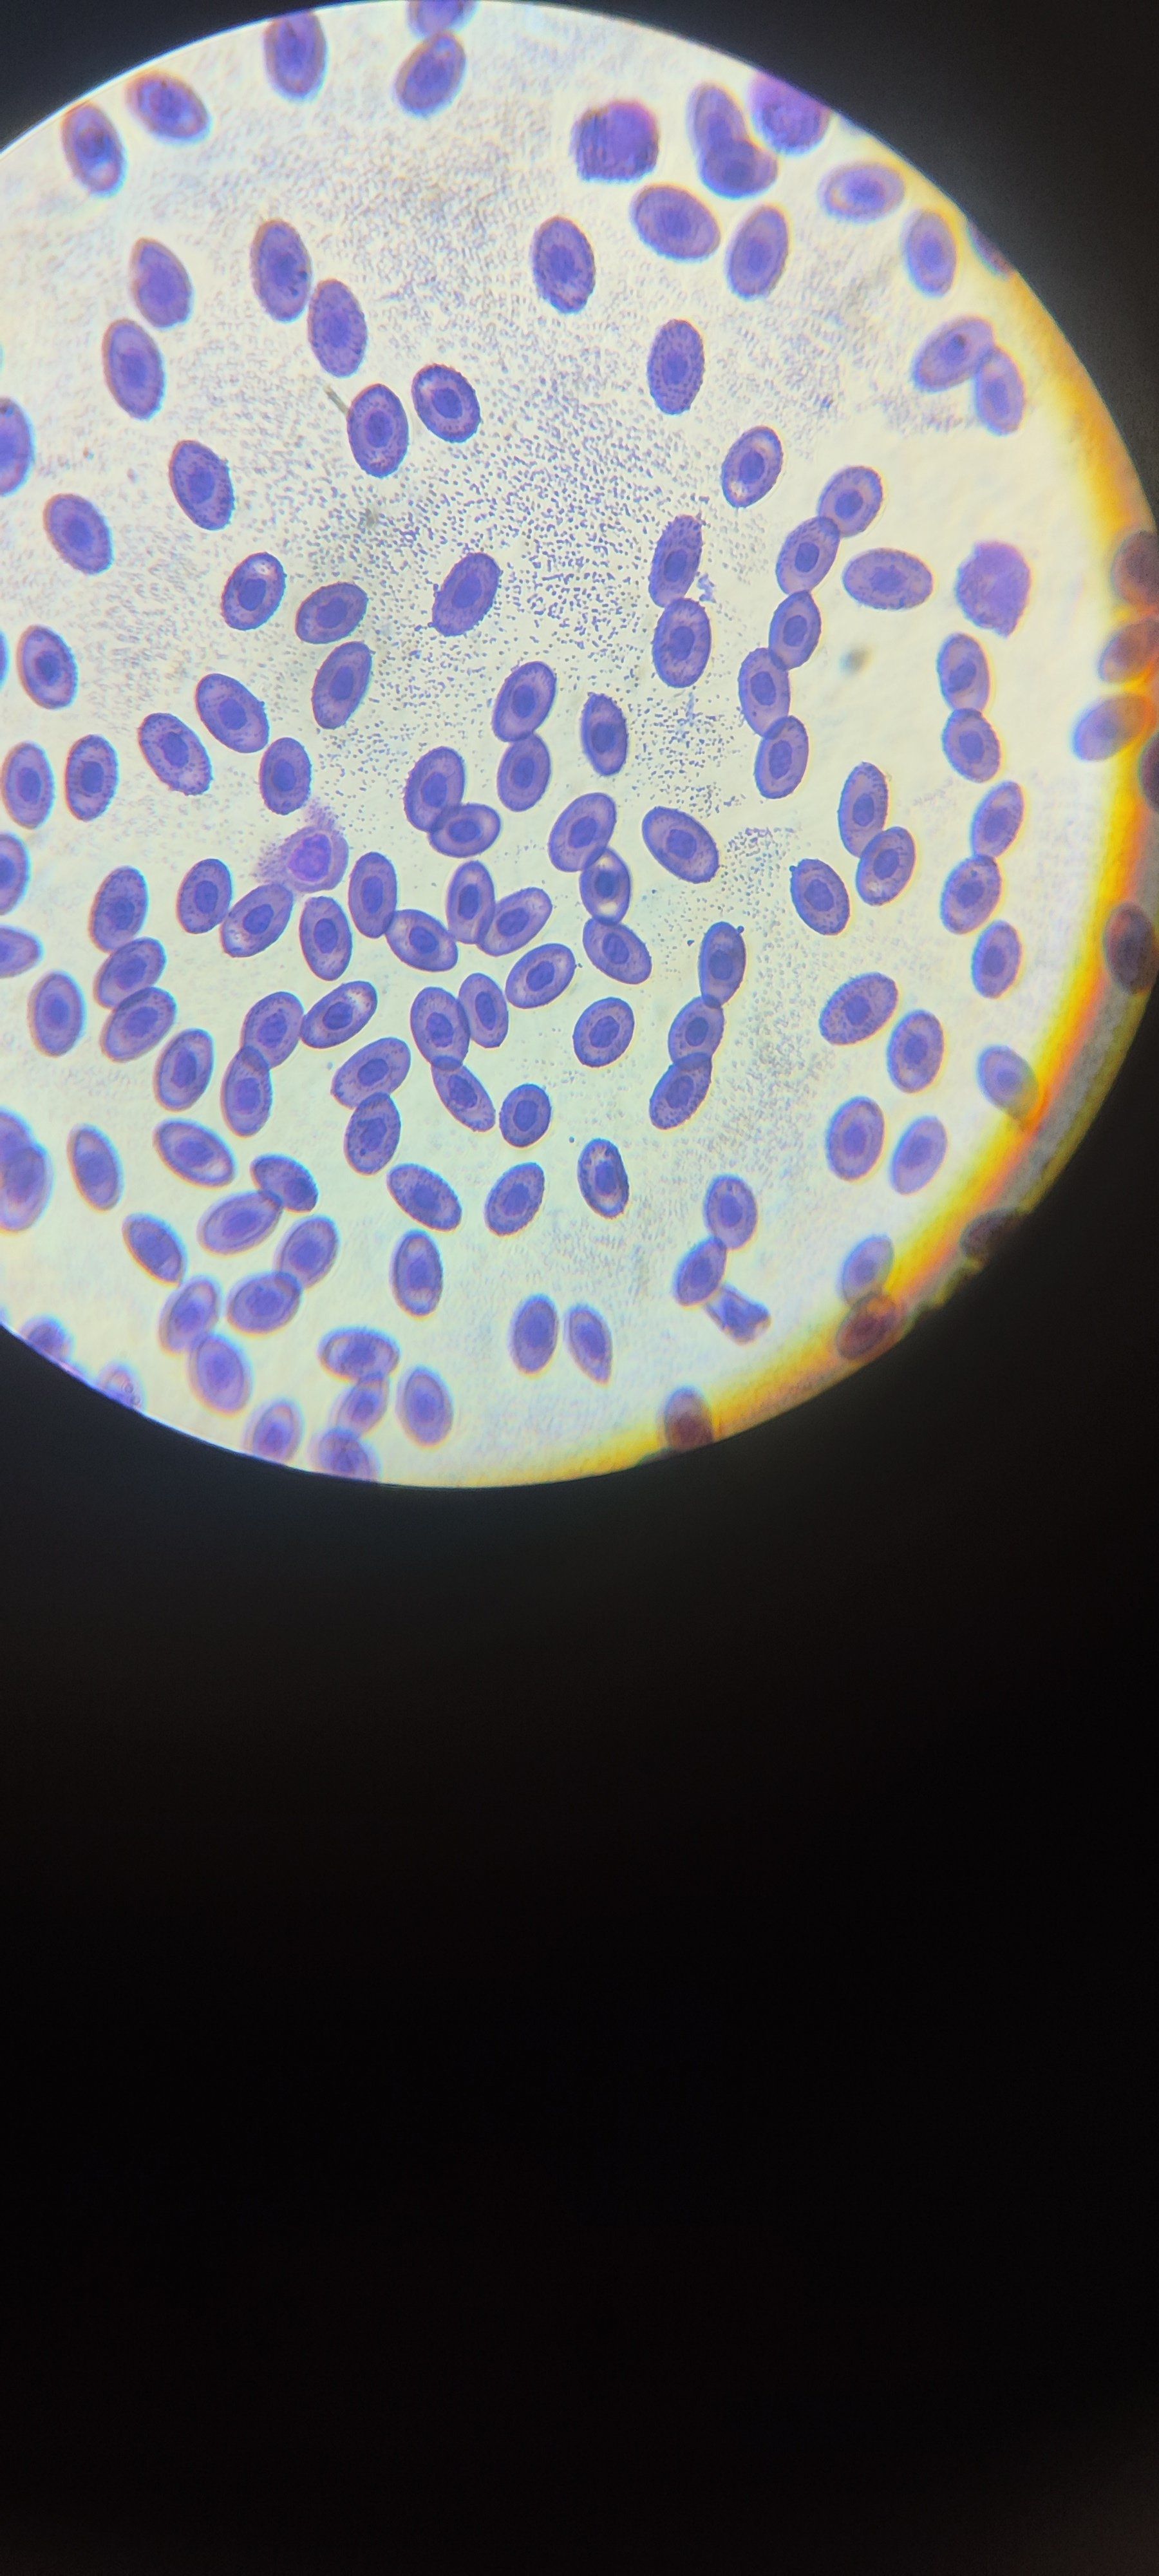
红细胞的动态壁纸

红辣椒表皮细胞图

显微镜下的红辣椒
图片尺寸900x1200
洋葱表皮,黑藻,红辣椒表皮细胞显微结构及生物绘图
图片尺寸972x607
中药显微—辣椒
图片尺寸1080x1440
辣椒表皮细胞的绘制
图片尺寸1440x1080
表皮细胞
图片尺寸2458x1280
鸢尾根横切面 p6:女贞叶横切面 p7:水稻叶横切面 p8:洋葱鳞片叶表皮
图片尺寸1207x1050
表皮细胞
图片尺寸960x1280
所有分类 高等教育 理学 实验二 徒手切片及植物细胞观察ppt 红辣椒中
图片尺寸1080x810
红细胞染色区分法
图片尺寸1080x1410
辣椒果皮红彤彤的有色体令人热血沸腾望眼欲穿找到了细胞的结构,必须
图片尺寸750x563
🔬 首先,我们来学习洋葱鳞叶表皮细胞的
图片尺寸1080x1410
🔬洋葱表皮细胞观察记
图片尺寸1080x1409
一个充满爱意的亲吻可能变成孩子的"毒药"
图片尺寸1366x2048 图片尺寸310x201
图片尺寸310x201
植物学实验报告手绘图
图片尺寸1920x2560
植物的叶绿体和白色提
图片尺寸1920x2560
显微镜下的红辣椒,细胞世界揭秘
图片尺寸720x960
红细胞形态特征:健康与疾病的差异
图片尺寸1280x1677
红细胞的动态壁纸
图片尺寸1800x4000
红细胞形态变化全解析:生命演变的微观奇迹
图片尺寸1546x1050










 图片尺寸310x201
图片尺寸310x201













 图片尺寸310x201
图片尺寸310x201